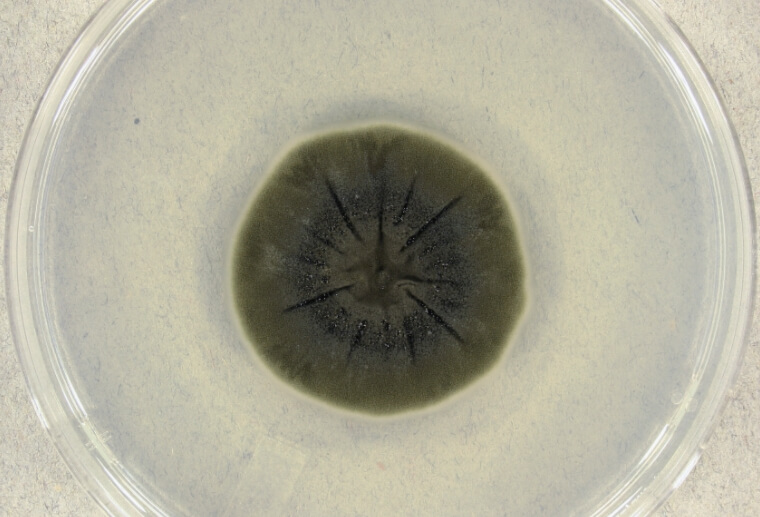
Защита от космического излучения. Грибок кладоспориум, который растет под воздействием радиации. Защита от космического излучения. Грибок кладоспориум, который растет под воздействием радиации. Фото.

Ученые предложили защищать астронавтов от радиации при помощи грибов
В 2025 году аэрокосмическое агентство NASA планирует отправить людей на Луну. Находясь на большом расстоянии от Земли, астронавты будут испытывать нехватку кислорода, неудобства из-за слабой гравитации и, самое главное — подвергаться космической радиации. Так называются опасные для человеческого здоровья лучи, источником которых являются Солнце и далекие галактики. Чтобы защитить астронавтов от опасного излучения, инженеры пытаются создать костюмы, которые не пропускают смертоносные лучи. Недавно ученые из США и Германии предложили покрывать поверхность космических кораблей, внеземных сооружений и космических костюмов слоем из поглощающих радиацию грибов. Самая интересная особенность этой идеи заключается в том, что под воздействием космических лучей грибы растут и становятся все более эффективными.

Растущий на Земле гриб может защитить астронавтов от космической радиации
Чем опасна космическая радиация?
Самую большую опасность для людей представляют частицы энергии, которые вылетают из Солнца в результате возникновения вспышек. Они называются солнечными космическими лучами (СКЛ) и представляют собой протоны, электроны и ядра, летящие с настолько огромной скоростью, что преодолевают 150 миллионов километров и достигают поверхности Земли за час. Частицы СКЛ опасны тем, что могут легко проходить через кожу человека и выделять энергию. Таким образом они разрушают встречающиеся на своем пути клетки или ДНК. Такие повреждения увеличивают риск возникновения рака или лучевой болезни.

Космическая радиация увеличивает риск развития опасных заболеваний
Находясь на Земле, люди не подвергаются воздействию опасных частиц. Дело в том, что наша планета окружена магнитосферой, которая отталкивает солнечные лучи. Свой вклад в защиту людей вносит и атмосфера, которая подавляет проходящие через нее частицы. Также под определенной защитой находятся члены экипажа МКС — станция находится в 408 километрах от нашей планеты, поэтому лучи не могут навредить космическим исследователям. Правда спустя год пребывания вне Земли, астронавтам все равно нужно возвращаться.
Читайте также: 10 фактов о реакции тела на экстремальные и опасные условия
Защита от космического излучения
А вот путешественники на Луну и Марс от опасного излучения защищены не будут. Конечно, ученые уже занимаются разработкой специальных костюмов и среди них есть хорошие варианты. Например, аэрокосмическое агентство NASA создало скафандры OCSS и xEMU, которые будут использованы во время упомянутого в начале статьи полета на Луну в 2025 году. Но разработкой занимаются и другие группы ученых — иногда они делятся весьма интересными идеями.

Космические костюмы OCSS и xEMU
Недавно в научном архиве BioRxiv была опубликована статья, в которой ученые предлагают защищать космических путешественников от радиации при помощи грибов. Речь идет о кладоспориуме (Cladosporium sphaerospermum), который растет путем поглощения радиации. В науке это явление принято называть радиосинтезом — это почти то же самое, как фотосинтез у растений. Грибы извлекают энергию из космических лучей так же, как растения из солнечного света.
Грибок кладоспориум, который растет под воздействием радиации
На Земле эти грибы отлично себя чувствуют в экстремальных условиях, которые образовались на территории Чернобыльской АЭС на Украине. В космосе им тоже хорошо — в 2019 году ученые отправили несколько образцов грибов на МКС и наблюдали их активным ростом. При этом они также обнаружили, что слой грибов способен защищать поверхности от воздействия радиации. Открытие было сделано в ходе эксперимента, где одну поверхность покрыли грибами, а другую оставили открытой — это был контрольный образец. Оказалось, что поверхность под слоем грибка толщиной 1,7 миллиметра была подвержена радиации на 2,17% меньше, чем открытая поверхность. Вдобавок к этому, грибок начал расти на 21% быстрее, чем на Земле.

Грибок кладоспориум хорошо растет в космической среде
В теории, если покрыть кладоспориумом космический корабль, внеземное жилье или костюм, можно защитить людей от опасного излучения. Только вот на данный момент есть большая проблема — чтобы защита была эффективной, слой гриба должен быть толщиной не менее 2,3 метра. По мнению ученых, такого же уровня защиты от радиации на Марсе можно достичь, просто построив жилище на глубине 3 метров под марсианским грунтом. Это гораздо проще, чем выращивать грибы.
Если вам интересны новости науки и техники, подпишитесь на наш канал в Яндекс.Дзен. Там вы найдете статьи, которые не были опубликованы на сайте!
Лично мне идея показалась интересной тем, что защитное покрытие способно расти под воздействием радиации, тем самым увеличивая защиту. Только вот я не думаю, что эта идея будет взята на вооружение при реальных космических путешествиях. А как считаете вы? Пишите в комментариях или в нашем Telegram-чате.



Новости, статьи и анонсы публикаций
Чат с читателямиСвободное общение и обсуждение материалов